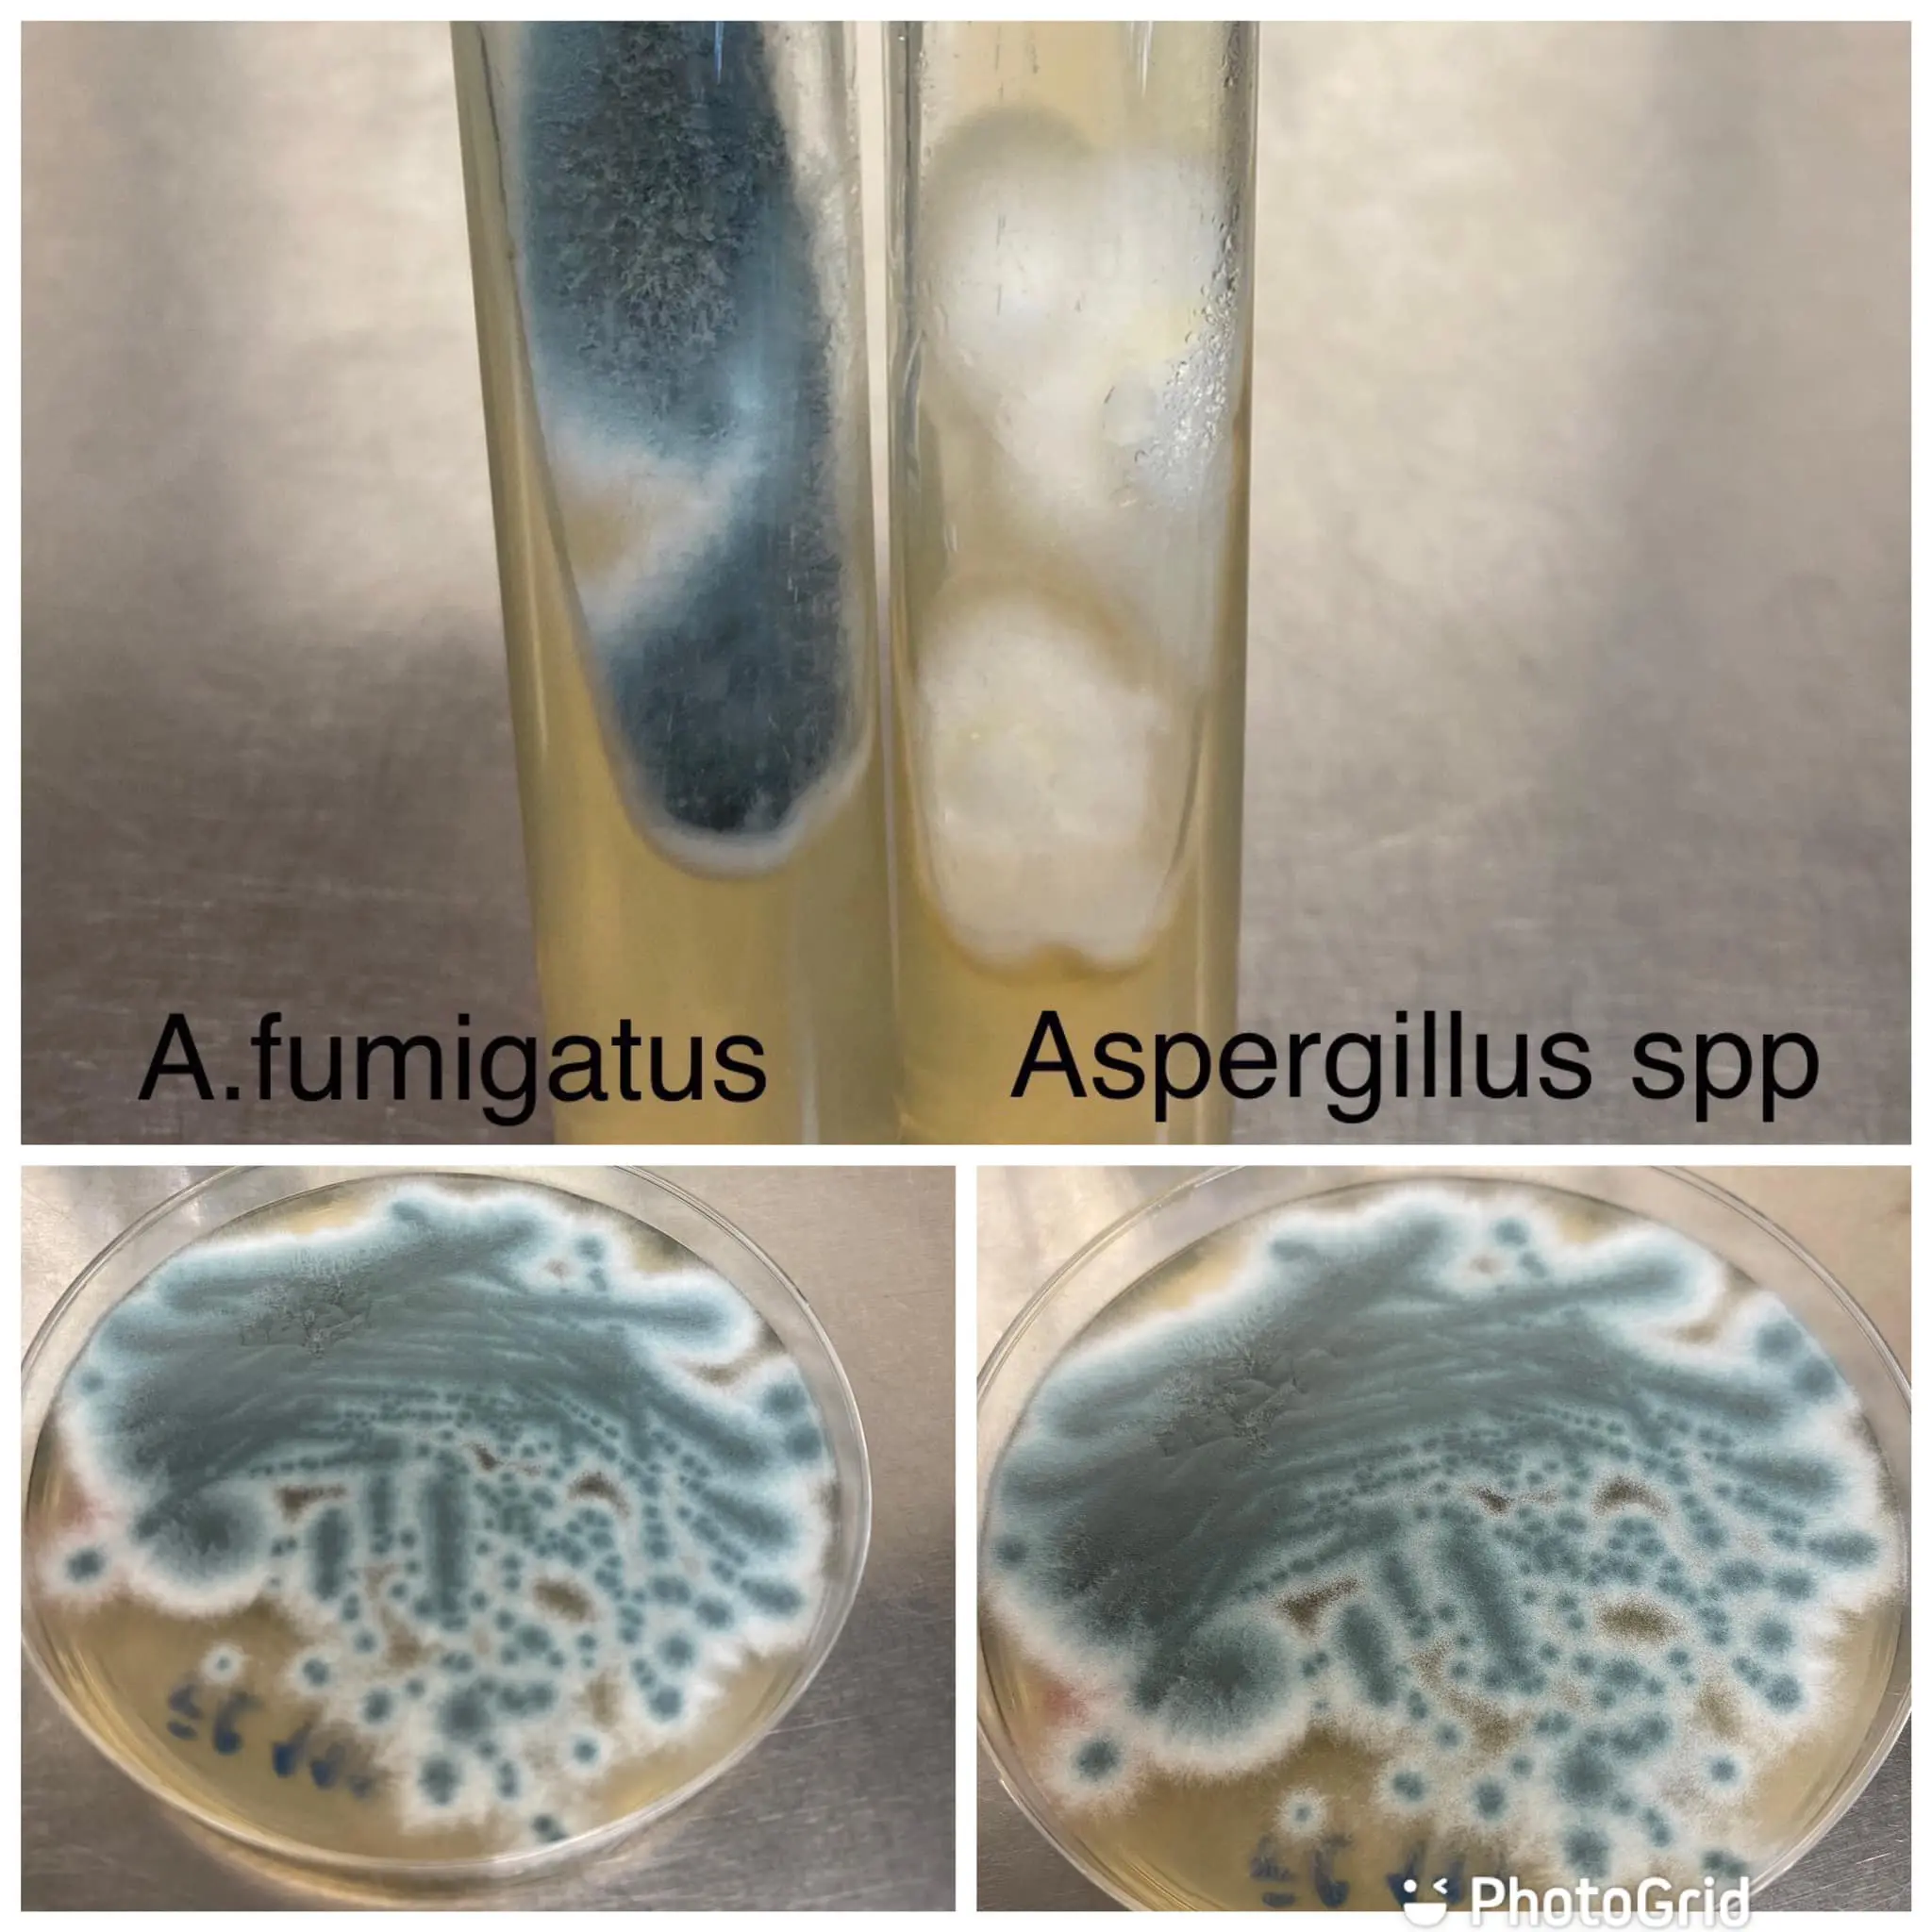
2-19

ภัยใกล้ตัว! คนแก่ต้องระวัง ติดเชื้อราในปอด หลังสูดดมความชื้นของหนังสือเก่า ที่กระดาษเปลี่ยนสีแล้ว พร้อมแนะให้ใส่หน้ากากอนามัยป้องกัน
เชื่อว่าหลาย ๆ คนก็คงเป็น เวลาที่เราจะทิ้งอะไรสักอย่าง แต่จู่ ๆ ก็เกิดเสียดาย โดยเฉพาะหนังสือเก่า ๆ หายาก แต่พอถึงเวลาที่ต้องทิ้งจริง ๆ หนังสือเหล่านั้นก็กระดาษเปลี่ยนสี อีกทั้งหนังสือเก่าบางเล่มก็จะมีการเกิดเชื้อราที่มาจากความชื้นของกระดาษ ที่หากสูดดมไปนาน ๆ ก็อาจเกิดอันตรายต่อร่างกายได้
ล่าสุดเพจเฟซบุ๊ก หมอมนูญ ลีเชวงวงศ์ FC ได้ออกมาแชร์ภาพของปอดที่กำลังติดเชื้อ เป็นอีกหนึ่งภัยใกล้ตัว เวลารื้อหนังสือเก่า ๆ ในบ้านนำไปทิ้ง โดยระบุว่า ผู้ป่วยชายอายุ 79 ปีเตรียมย้ายบ้านที่บางแค กทม.ไปอยู่คอนโด ให้คนในบ้าน 2 คนรื้อหนังสือเก่า ๆ ที่เก็บสะสมไว้มากกว่า 20 ปี กระดาษหนังสือเปลี่ยนเป็นสีน้ำตาล เพื่อนำไปทิ้ง และเก็บไว้เพียงบางเล่ม ผู้ป่วยนั่งอยู่ในห้องหนังสือเป็นเวลา 2 ชั่วโมงขณะรื้อหนังสือ โดยไม่ได้ใส่หน้ากากอนามัย เมื่อวันที่ 16 กันยายน 2565 หลังจากนั้น 9 วันเริ่มมีไข้ ไอแห้งๆ เหนื่อยบ้าง
ผู้ป่วยเป็นโรคเส้นประสาทอักเสบแบบระยะเรื้อรัง (Chronic inflammatory demyelinating polyradiculoneuropathy หรือ CIDP หรือโรคซีไอดีพี) ทำให้แขนขาชาและอ่อนแรง 3 เดือน กำลังรักษาด้วยยาสเตียรอยด์ขนาดสูงและยากดภูมิเซลเซ็ป (cellcept) ตรวจร่างกาย มีไข้ อุณหภูมิ 38.1 องศาเซลเซียส ฟังเสียงปอดปกติ เอกซเรย์ปอดผิดปกติทั้ง 2 ข้าง

ทำคอมพิวเตอร์สแกนปอด พบโพรงเล็ก ๆ ในบริเวณปอดที่มีปื้นสีขาวหลายตำแหน่งในปอดทั้ง 2 ข้าง ส่องกล้องเข้าไปดูในปอด พบเสมหะสีขาวเล็กน้อย ส่งเสมหะที่ดูดจากหลอดลมไปตรวจ ย้อมพบเชื้อราสาย ไม่พบวัณโรค เพาะเชื้อราขึ้นแอสเปอร์จิลลัส ฟูมิกาทัส (aspergillus fumigatus) และ aspergillus spp อีกตัวหนึ่งไม่ทราบสปีชี่ส์ (ดูรูป) ส่งน้ำล้างปอดวัดระดับ bronchial aspergillus galactomannan ให้ผลบวก ยืนยันการติดเชื้อรา aspergillus
สรุปแล้ว ผู้ป่วยรายนี้มีภูมิคุ้มกันบกพร่องจากกินยาสเตียรอยด์และยากดภูมิ ติดเชื้อรา aspergillus จากการสูดดมหายใจสปอร์ของเชื้อรา aspergillus ที่เจริญงอกอยู่ในเนื้อกระดาษที่ชื้นของหนังสือเก่าๆลอยออกมาในอากาศขณะหนังสือถูกรื้อ เข้าไปในปอด ทำให้เกิดโรคแอสเปอร์จิลโลสิส ปอดติดเชื้อราแอสเปอร์จิลลัสชนิดรุกราน (invasive pulmonary aspergillosis)
ให้การรักษาด้วยยาฆ่าเชื้อรา ชนิดกินวอริโคนาโซล (voriconazole) คนไข้ค่อยๆดีขึ้น คนที่ช่วยย้ายหนังสือ ไม่มีใครป่วย ถึงจะสูดดมสปอร์ของเชื้อรา เพราะสุขภาพแข็งแรง มีภูมิต้านทานดี
โดยหมอ มนูญ ก็ได้ให้คำแนะนำสำหรับคนที่ร่างกายอ่อนแอ มีโรคประจำตัว มีภูมิคุ้มกันต่ำ โดยให้ใส่หน้ากากอนามัยเวลารื้อหนังสือเก่า ๆ ในบ้าน หรือทางที่ดีที่สุด หลีกเลี่ยงอยู่ในห้องที่กำลังรื้อหนังสือ เพราะอาจหายใจเอาสปอร์ของเชื้อราเข้าปอด ทำให้ติดเชื้อราในปอดได้
ติดตามข่าวสาร Bright Today ช่องทางอื่น ๆ
Website : BRIGHT TODAY
Facebook : BRIGHT TV
Line Today : BRIGHT TODAY











